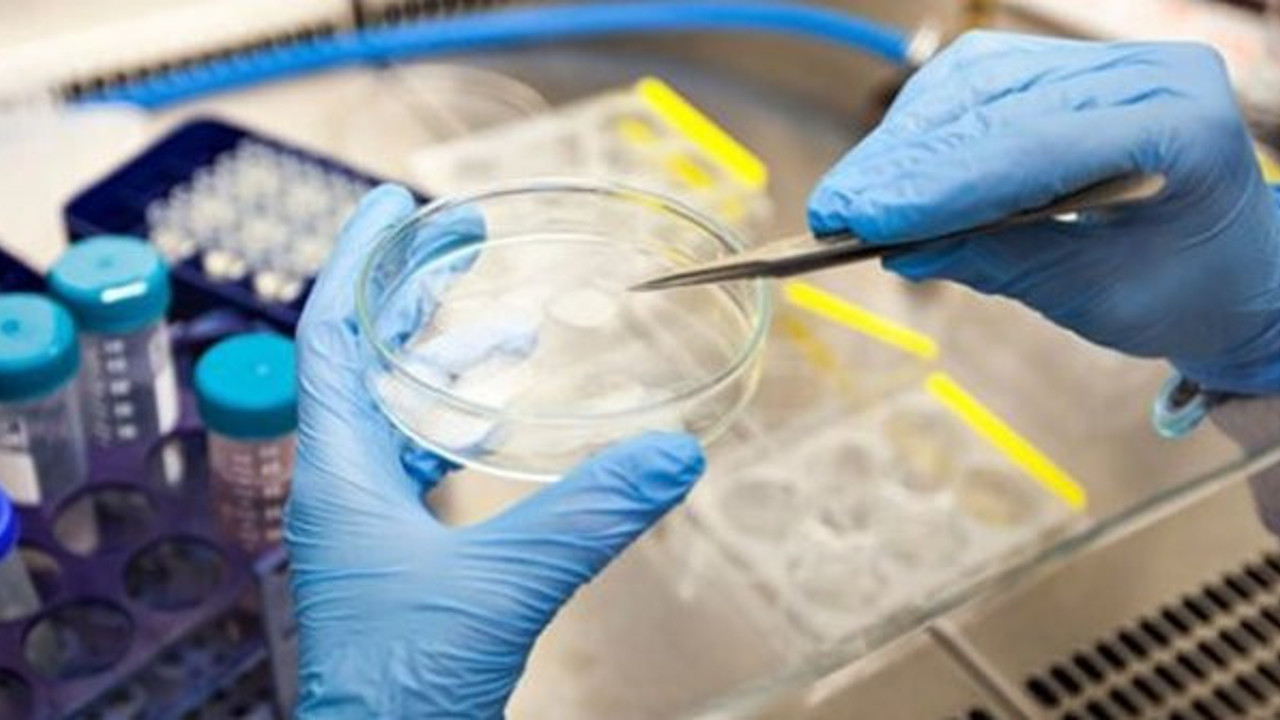
Ünlü İngiliz gazetesi gizli belgeyi açıkladı: Hükümet salgın için bir sene önceden uyarıldı

İngiliz Guardian gazetesi, İngiltere'de bakanların geçen yıl bir bilgilendirme metniyle, büyük sosyal ve ekonomik sonuçlara yol açacak dirençli bir virüs salgınına karşı hazırlıklı olmaları konusunda uyarıldıklarını ortaya koydu.
Gazeteye sızdırılan gizli belgede, hafif seyreden bir salgında bile on binlerce kişinin hayatını kaybedebileceği belirtiliyor ve hükümetin salgın ihtimaline karşı alması gereken önlemler ile bu önlemleri almaması halinde olabilecekler sıralanıyor.
İngiltere'de Covid-19 nedeniyle hayatını kaybedenlerin sayısı 20.000'e yaklaştı. İngiltere Sağlık Hizmetleri (NHS) Medikal Direktörü Prof. Stephen Powis, "Eğer ölü sayısını 20.000'in altında tutabilirsek, bu salgında çok iyi bir sınav vermiş olacağız" demişti.
"HEM YÜKSEK ORANDA BULAŞICI HEM DE YÜKSEK ORANDA ÖLDÜRÜCÜ OLABİLİR"
Belgede yer alan hükümete yönelik öneriler arasında koruyucu ekipman stoklanması, diğer temel araç gereçleri satın alma anlaşmaları yapması, filyasyon prosedürlerini hazır hale getirmesi ve ölüm sayısında aşırı artış yaşanması durumunda atacağı adımlara yönelik bir plan hazırlaması tavsiye ediliyor.
Yurt dışındaki İngilizlere yardım etme ve onları ülkeye geri getirmeye yönelik planlar yapılması da öncelikler arasında sıralanıyor.
İngiltere'de hükümet salgına hazırlıksız yakalandığı, özellikle de sağlık çalışanları için yeterli koruyucu ekipman olmadığı gerekçesiyle yoğun eleştiri altında.
600 sayfadan fazla olan belgede, sadece bulaşıcı bir grip salgınının olası etkileri değil, spesifik olarak bir koronavirüs salgınının (yakın zamanda görülen SARS ve MERS de koronavirüstü) olası etkileri de inceleniyor.
Geçmişteki güvenlik ve sağlık riski kayıtlarından yola çıkılan belgede, "Yeni bir virüs salgını hem yüksek oranda bulaşıcı hem de yüksek oranda öldürücü olabilir" deniyor.
Guardian gazetesi hükümetin salgın öncesindeki dönemde yaptıkları hazırlıklara ilişkin detaylı bilgi vermediğini yazdı. Ancak habere göre hükümet, 'sıfırdan başladıklarını söylemenin de haksızlık olacağını' ifade etti ve son yıllarda tatbikat planlamaları yaptıklarını belirtti.
MUHALEFET, HÜKÜMETİ AÇIKLAMA YAPMAYA ÇAĞIRIYOR
Hükümet sözcüsü, hükümetin acil durum yanıtının insan hayatını ve işletmeleri korumak olduğunu söyledi:
"Yanıt, ihtiyacı olan herkese tedavi sağlayabilmesi için NHS'in gerekli tüm desteği aldığından ve işletmelerin korunduğundan, işçilere güvence verildiğinden emin olmayı içerdi" denildi.Ancak İngiltere'de hükümet üzerindeki baskı artıyor.
Ana muhalefetteki İşçi Partisi'nin gölge kabinesinden Rachel Reeves, ifşaların "endişe verici olduğunu ve hükümetin koronavirüs kaynaklı bir pandemiye karşı planlama ve hazırlık konularında soru işareti yarattığını" söyledi.Reeves, kabine işlerinden sorumlu Bakan Michael Gove'dan Pazartesi günü Parlamento'da "bu belgenin okunup okunmadığına ve hangi hazırlıkların yapıldığına dair" bir açıklama yapmasını talep etti.
Çarşamba günü İşçi Partisi lideri Keir Starmer, bakanların "sokağa çıkma sınırlandırmaları ilan etme, test yapma ve koruyucu ekipman sağlamada neden yavaş kalındığını" açıklamalarını istedi.
Hükümet için domuz gribi konusunda rapor hazırlayan ve Perşembe günü BBC'ye konuşan Dame Deirdre Hine, hükümeti salgın konusunda yavaş davranmakla suçladı, "Bence kayıtsız kaldık" dedi.